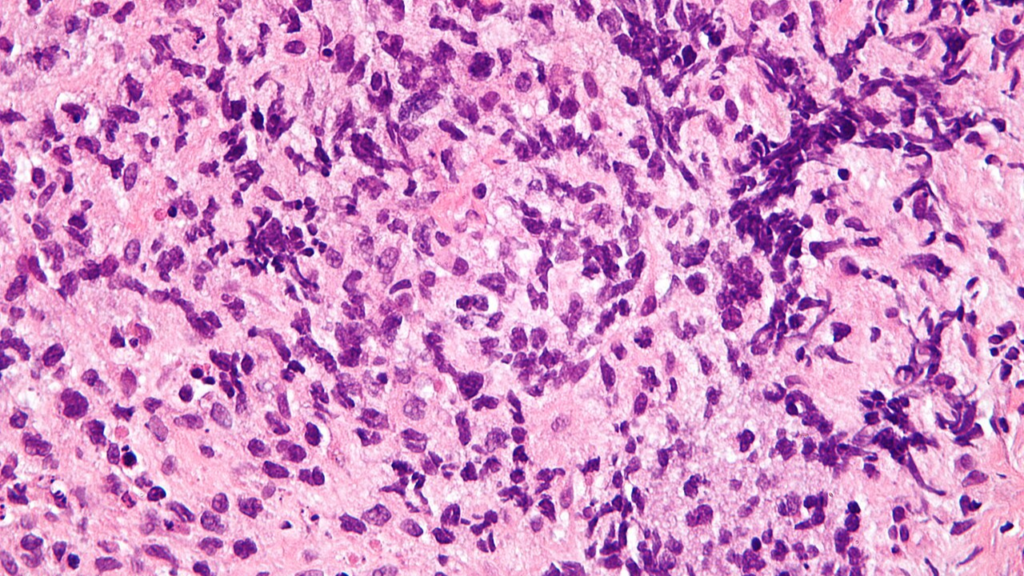

Au cœur du thorax, entre les poumons, le médiastin constitue une région anatomique essentielle où se concentrent de nombreuses structures vitales. Parmi elles, les ganglions lymphatiques jouent un rôle clé dans la défense immunitaire. Lorsqu’ils augmentent de volume, on parle d’adénopathies médiastinales. Ce terme, fréquemment utilisé en imagerie médicale et en pneumologie, recouvre des réalités cliniques variées, allant de réactions bénignes à des pathologies plus graves.
- Le médiastin et le rôle des ganglions lymphatiques
- Les causes possibles des adénopathie médiastinales
- Symptômes et circonstances de découverte
- L’imagerie au cœur du diagnostic
- Le recours aux prélèvements pour un diagnostic précis
- Les enjeux en cancérologie thoracique
- Les adénopathies médiastinales dans les maladies inflammatoires
- Suivi et évolution des adénopathies médiastinales
- Une approche multidisciplinaire indispensable
- Conclusion
La découverte d’adénopathie médiastinales suscite souvent des interrogations, voire des inquiétudes, tant chez les patients que chez les professionnels de santé. Leur interprétation repose sur une analyse rigoureuse du contexte clinique, des caractéristiques radiologiques et, parfois, des examens complémentaires plus invasifs. Comprendre ces anomalies implique d’explorer à la fois l’anatomie, les mécanismes physiopathologiques et les approches diagnostiques modernes.
Le médiastin et le rôle des ganglions lymphatiques
Le médiastin est un espace central du thorax, situé entre les deux poumons. Il abrite des organes majeurs tels que le cœur, l’œsophage, la trachée, ainsi que de nombreux vaisseaux sanguins et nerfs. Les ganglions lymphatiques médiastinaux y sont répartis selon des stations bien définies, utilisées notamment en cancérologie pour évaluer la propagation de certaines maladies.
Ces ganglions font partie du système lymphatique, un réseau complexe chargé de filtrer la lymphe et de détecter la présence d’agents pathogènes. Lorsqu’une infection, une inflammation ou un processus tumoral survient, les ganglions peuvent réagir en augmentant de taille. Cette augmentation, appelée adénopathie, constitue un signal d’alerte mais ne permet pas, à elle seule, de poser un diagnostic précis.
Dans le cas des adénopathies médiastinales, leur localisation profonde rend leur détection clinique difficile. Elles sont le plus souvent découvertes de manière fortuite lors d’un examen d’imagerie, comme une radiographie thoracique ou un scanner.
Les causes possibles des adénopathie médiastinales
Les adénopathies médiastinales peuvent avoir des origines très diverses. Leur interprétation nécessite une analyse fine du contexte médical, de l’âge du patient, de ses antécédents et des symptômes associés.
Parmi les causes les plus fréquentes figurent les infections. Certaines maladies infectieuses, comme la tuberculose ou des infections virales, peuvent entraîner une réaction des ganglions médiastinaux. Dans ces situations, l’augmentation de volume est souvent liée à une activation du système immunitaire.
Les maladies inflammatoires constituent une autre catégorie importante. La sarcoïdose, par exemple, se manifeste fréquemment par des adénopathies médiastinales bilatérales. Cette affection, d’origine encore mal comprise, entraîne la formation de granulomes dans différents organes.
Les pathologies tumorales représentent également une cause majeure. Les cancers bronchiques peuvent s’accompagner d’une atteinte ganglionnaire médiastinale, traduisant une extension de la maladie. Les lymphomes, qui sont des cancers du système lymphatique, se manifestent souvent par des adénopathies volumineuses et diffuses.
Enfin, certaines causes plus rares doivent être envisagées, comme des maladies auto-immunes ou des réactions à des substances inhalées. Cette diversité étiologique rend indispensable une approche diagnostique méthodique.
Symptômes et circonstances de découverte
Dans de nombreux cas, les adénopathies médiastinales sont asymptomatiques. Elles sont alors découvertes de manière fortuite lors d’un examen réalisé pour une autre raison. Cette situation est fréquente, notamment dans le cadre de bilans radiologiques systématiques.
Lorsque des symptômes sont présents, ils sont souvent liés à la cause sous-jacente plutôt qu’aux ganglions eux-mêmes. Une infection peut s’accompagner de fièvre, de fatigue ou de toux. Une pathologie tumorale peut entraîner une altération de l’état général, une perte de poids ou des douleurs thoraciques.
Dans certains cas, des adénopathies volumineuses peuvent comprimer des structures voisines. Cette compression peut provoquer des difficultés respiratoires, une toux persistante ou des troubles de la déglutition. Toutefois, ces manifestations restent relativement rares et surviennent généralement à un stade avancé.
L’imagerie au cœur du diagnostic
L’identification des adénopathies médiastinales repose principalement sur l’imagerie médicale. La radiographie thoracique constitue souvent le premier examen, mais elle peut manquer de précision pour caractériser les anomalies.
Le scanner thoracique, ou tomodensitométrie, représente l’outil de référence. Il permet de visualiser avec précision la taille, la forme et la localisation des ganglions. Certains critères, comme un diamètre supérieur à un centimètre, peuvent orienter vers une adénopathie significative, mais ils ne suffisent pas à déterminer sa nature.
L’imagerie par tomographie par émission de positons, souvent couplée au scanner, apporte des informations supplémentaires sur l’activité métabolique des ganglions. Une fixation importante peut suggérer un processus tumoral ou inflammatoire actif, mais elle n’est pas spécifique.
L’interprétation des images nécessite une expertise particulière. Elle doit être corrélée aux données cliniques et biologiques pour orienter la suite de la prise en charge.
Le recours aux prélèvements pour un diagnostic précis
Lorsque l’origine des adénopathies médiastinales reste incertaine, un prélèvement peut être nécessaire. L’analyse histologique des tissus permet d’identifier avec précision la nature de l’atteinte.
Plusieurs techniques existent pour accéder aux ganglions médiastinaux. La fibroscopie bronchique avec ponction transbronchique guidée par échographie est aujourd’hui largement utilisée. Elle permet de prélever des échantillons de manière relativement peu invasive.
Dans certains cas, une médiastinoscopie peut être indiquée. Cette intervention chirurgicale consiste à introduire un instrument dans le médiastin pour visualiser et biopsier les ganglions. Bien que plus invasive, elle offre une grande précision diagnostique.
Le choix de la technique dépend de plusieurs facteurs, notamment de la localisation des ganglions et de l’état général du patient. L’objectif est toujours d’obtenir un diagnostic fiable tout en minimisant les risques.
Les enjeux en cancérologie thoracique
Dans le contexte des cancers thoraciques, les adénopathies médiastinales revêtent une importance particulière. Leur présence peut indiquer une propagation de la maladie au-delà de la tumeur initiale.
Cette information est essentielle pour établir le stade du cancer, un élément déterminant dans le choix du traitement. Une atteinte ganglionnaire médiastinale peut orienter vers des stratégies thérapeutiques spécifiques, comme la chimiothérapie ou la radiothérapie, parfois en association avec la chirurgie.
L’évaluation précise des ganglions est donc une étape clé du bilan initial. Elle permet d’adapter la prise en charge et d’optimiser les chances de succès du traitement.
Les adénopathies médiastinales dans les maladies inflammatoires
En dehors du contexte tumoral, les adénopathies médiastinales jouent un rôle important dans le diagnostic de certaines maladies inflammatoires. La sarcoïdose en est l’exemple le plus emblématique.
Dans cette affection, les ganglions médiastinaux sont souvent atteints de manière symétrique. Leur aspect à l’imagerie, associé à d’autres signes cliniques et biologiques, permet d’orienter le diagnostic. Toutefois, une confirmation histologique est parfois nécessaire.
D’autres maladies, comme certaines pneumopathies interstitielles ou des affections auto-immunes, peuvent également s’accompagner d’adénopathies médiastinales. Leur interprétation nécessite une collaboration étroite entre pneumologues, radiologues et pathologistes.
Suivi et évolution des adénopathies médiastinales
Une fois identifiées, les adénopathies médiastinales doivent être surveillées, surtout lorsque leur cause n’est pas immédiatement déterminée. Le suivi repose généralement sur des examens d’imagerie répétés, permettant d’évaluer l’évolution de la taille et de l’aspect des ganglions.
Une diminution de taille peut suggérer une origine bénigne ou une réponse au traitement. À l’inverse, une augmentation ou une modification de l’aspect peut nécessiter des investigations complémentaires.
La durée et la fréquence du suivi dépendent du contexte clinique. Dans certains cas, une simple surveillance suffit. Dans d’autres, une prise en charge active est indispensable.
Une approche multidisciplinaire indispensable
La complexité des adénopathies médiastinales impose une prise en charge multidisciplinaire. Aucun spécialiste ne peut, à lui seul, couvrir l’ensemble des aspects diagnostiques et thérapeutiques.
Les radiologues jouent un rôle central dans l’identification et la caractérisation des ganglions. Les pneumologues interviennent dans l’évaluation clinique et la réalisation de certains prélèvements. Les oncologues et les hématologues sont impliqués en cas de pathologie tumorale.
Cette collaboration permet d’élaborer une stratégie adaptée à chaque patient, en tenant compte des spécificités de sa situation. Elle garantit également une meilleure coordination des soins.
Conclusion
Les adénopathies médiastinales constituent un signe clinique et radiologique fréquent, mais complexe à interpréter. Leur présence ne correspond pas à un diagnostic en soi, mais à une manifestation pouvant révéler des pathologies très diverses, allant de situations bénignes à des maladies graves.
L’approche diagnostique repose sur une analyse rigoureuse, combinant données cliniques, imagerie et, si nécessaire, examens histologiques. Cette démarche progressive permet d’éviter les conclusions hâtives et d’orienter la prise en charge de manière adaptée.
Dans un contexte médical en constante évolution, marqué par les progrès de l’imagerie et des techniques de prélèvement, la compréhension des adénopathies médiastinales continue de s’affiner. Elle illustre la nécessité d’une médecine à la fois précise, collaborative et centrée sur le patient.
vous pouvez également lire: la crete et la grece




